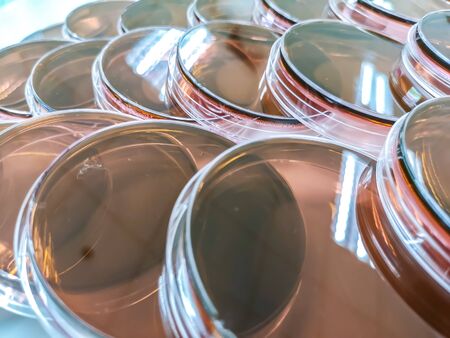
Eosin methylene blue agarの写真素材

写真素材 - Eosin methylene blue agar
キーワード
- agar
- analysis
- background
- bacteria
- bacterial
- bacteriology
- bacterium
- biology
- biotechnology
- blue
- clean
- closeup
- culture
- disease
- dish
- dishes
- emb
- eosin
- eosin methylene blue
- equipment
- experiment
- growth
- health
- health care
- inoculum
- isolated
- lab
- laboratory
- laboratory equipments
- media
- medical
- medicine
- medium
- methylene
- microbiology
- no one
- no people
- petri
- plate
- plates
- protection
- research
- safe
- safety
- science
- scientific
- still life
- technology
- test
- white
類似作品
Laboratory test...
Seats in confer...
Menthol Eucalyp...
A Petri dish (a...
Abstract transp...
Two schales iso...
photo blue pill
Abstract blue s...
Blue slime spll...
underwater worl...
Blue paint on a...
A female scient...
One stylish pla...
Psilocybin mush...
Moon jellyfish,...
Blue medicine d...
Jelly
Jellyfish in th...
art background
empty plate on ...
Plastic Bottles...
macro of bacter...
Clear dishes ar...
Laboratory glas...
Abstract blue b...
abstract blue g...
underwater worl...
Dental milling ...
culture dish on...
Petri dish with...
culture dish on...
technician rese...
Jellyfish in wa...
Octopus suckers
Texture swatch ...
On the surface ...
Blue jellyfish ...
led lamps blue ...
Petri dishes cl...
Selective focus...
Photo Picture o...
Transparent blu...
Laboratory glas...
hair vitamin se...
jellyfish biolu...
Water Spill
Researchers wor...